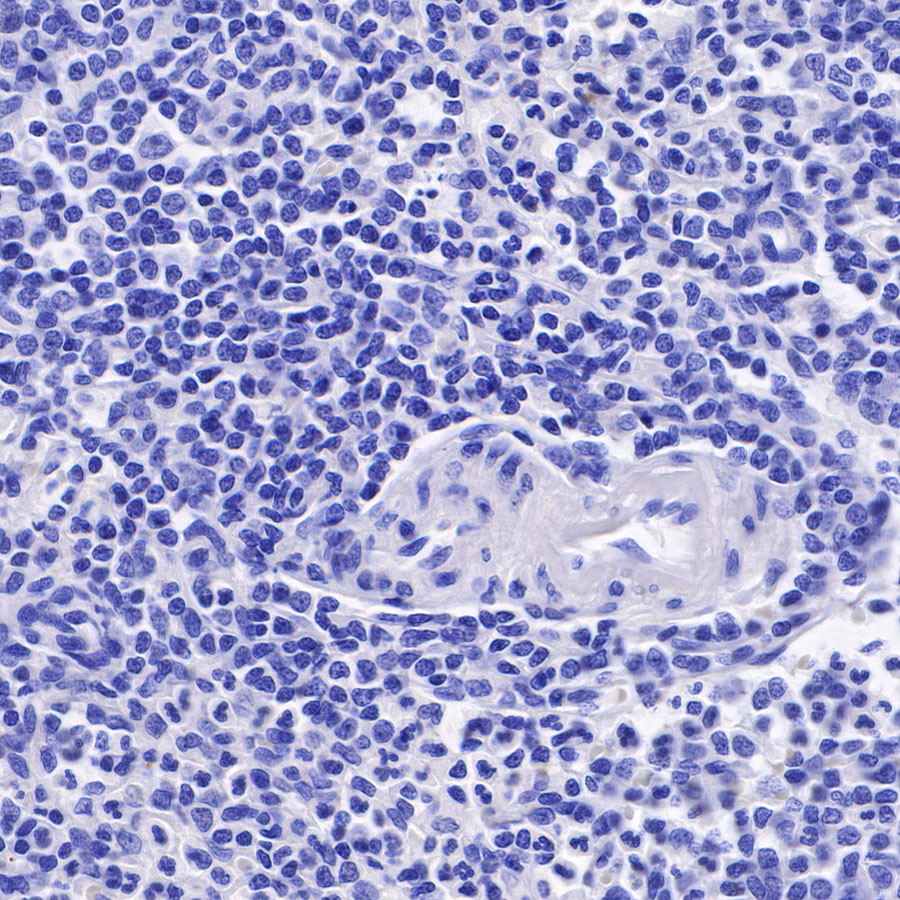
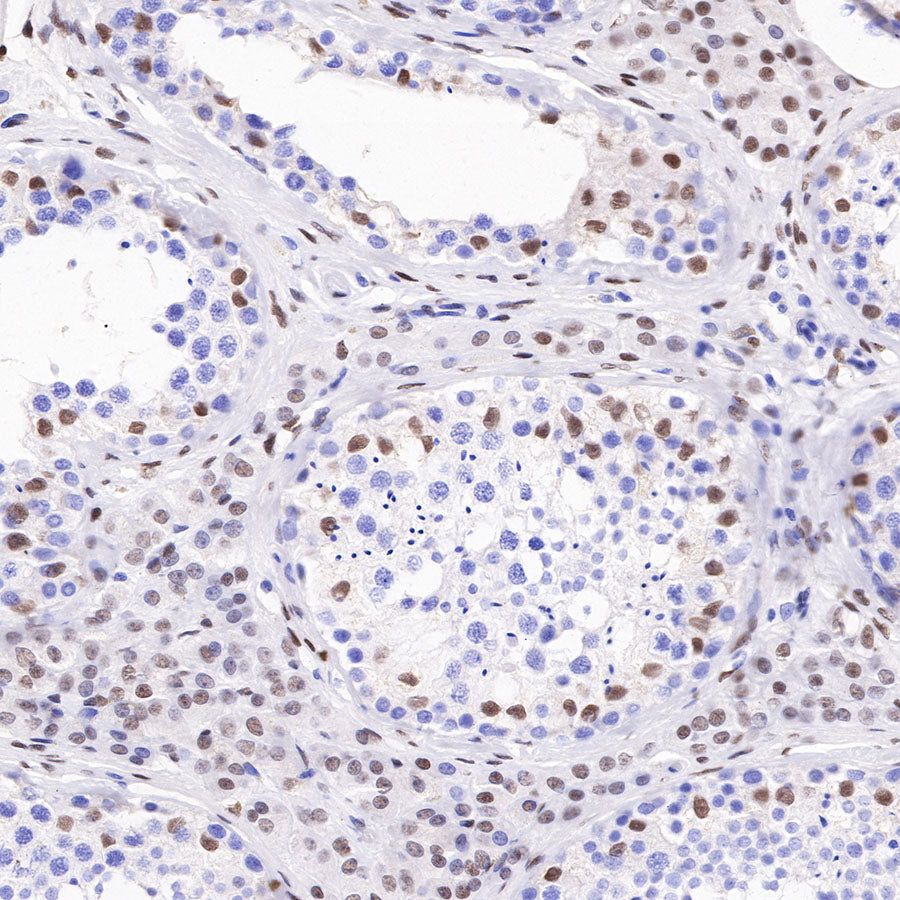

Product Specification
| Host |
Rabbit |
| Antigen |
Androgen Receptor |
| Synonyms |
AR, Dihydrotestosterone receptor, Nuclear receptor subfamily 3 group C member 4 |
| Immunogen |
N/A |
| Location |
Nucleus |
| Accession |
P10275 |
| Clone Number |
SDT-R167 |
| Antibody Type |
Recombinant mAb |
| Application |
WB, IHC-P, ICC, ICFCM |
| Reactivity |
Hu |
| Purification |
Protein A |
| Concentration |
0.5 mg/ml |
| Tag |
N/A |
| Physical Appearance |
Liquid |
| Storage Buffer |
PBS, 40% Glycerol, 0.05% BSA, 0.03% Proclin 300 |
| Stability & Storage |
12 months from date of receipt / reconstitution, -20 °C as supplied |
Dilution
| application |
dilution |
species |
| WB |
1:1000 |
null |
| IHC-P |
1:250 |
null |
| ICFCM |
1:500 |
null |
| ICC |
1:500 |
null |
Background
The androgen receptor (AR), ligand-induced transcription factor, is expressed in primary prostate cancer and in metastases. AR regulates multiple cellular events, proliferation, apoptosis, migration, invasion, and differentiation. Its expression in prostate cancer cells is regulated by steroid and peptide hormones [PMID: 24384911]. The elucidation of the structures of the AR DNA binding domain (DBD) and ligand binding domain (LBD) provides a new framework for understanding the functions of this receptor and leads to the development of rational drug design for the treatment of prostate cancer [PMID: 24909511].